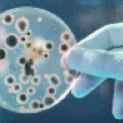

<\/a>
\n\t\t\t\t\t\t \n\t\t\t\t\t<\/div><\/div><\/div>\n
\n\t\t\t\t\t<\/div><\/div><\/div>\n\t\t\tSide effects induced by antipsychotic drugs affect patient movement and cause muscle rigidity, tremor, parkinsonism, and akathisia (inability to remain motionless), among others. They are a major cause for abandonment of this type of treatments. <\/p>\n
This technology will be incorporated into Neurofarmagen, a genetic test developed by AB-Biotics which identifies most optimum medication for each patient by analysing their DNA, extracted from a sample of saliva. The information provided by the new method helps doctors to identify the most appropriate treatment (drug and dose) for each patient. Neurofarmagen is currently marketed in Spain, through Almirall; in Brazil, through GlaxoSmithKline, and in Mexico, through Scienta Farma. <\/p>\n
Inventors of the patent are Am\u00e0lia Lafuente, Cristina Malagelada and Sergi Mas from the UB; Patricia Gass\u00f3 from IDIBAPS and UB, and Miguel Bernardo from UB, Hospital Cl\u00ednic and CIBERSAM. <\/p>\n","protected":false},"excerpt":{"rendered":"
The University of Barcelona (UB), the August Pi i Sunyer Biomedical Research Institute (IDIBAPS), the Hospital Cl\u00ednic of Barcelona and the Centre for Biomedical Network Research on Mental Health (CIBERSAM) have developed a technology that allows to predict if the risk of a patient treated with antipsychotic drugs developing extrapyramidal symptoms, which affect the central nervous system. At the beginning of the year, researchers applied for a patent that the Bosch i Gimpera Foundation (FGB), based in the Parc Cient\u00edfic de Barcelona, licenced recently to the biotechnological company AB-Biotics. <\/p>\n","protected":false},"author":1,"featured_media":0,"comment_status":"closed","ping_status":"open","sticky":false,"template":"","format":"standard","meta":{"_acf_changed":false,"inline_featured_image":false,"footnotes":""},"categories":[8],"tags":[],"class_list":["post-48618","post","type-post","status-publish","format-standard","category-uncategorized"],"acf":[],"yoast_head":"\n
The Bosch i Gimpera Foundation licences a patent to the AB-Biotics. - Parc Cient\u00edfic de Barcelona<\/title>\n<meta name=\"robots\" content=\"index, follow, max-snippet:-1, max-image-preview:large, max-video-preview:-1\" \/>\n<link rel=\"canonical\" href=\"https:\/\/www.pcb.ub.edu\/en\/the-bosch-i-gimpera-foundation-licences-a-patent-to-the-ab-biotics\/\" \/>\n<meta property=\"og:locale\" content=\"en_US\" \/>\n<meta property=\"og:type\" content=\"article\" \/>\n<meta property=\"og:title\" content=\"The Bosch i Gimpera Foundation licences a patent to the AB-Biotics. - Parc Cient\u00edfic de Barcelona\" \/>\n<meta property=\"og:description\" content=\"The University of Barcelona (UB), the August Pi i Sunyer Biomedical Research Institute (IDIBAPS), the Hospital Cl\u00ednic of Barcelona and the Centre for Biomedical Network Research on Mental Health (CIBERSAM) have developed a technology that allows to predict if the risk of a patient treated with antipsychotic drugs developing extrapyramidal symptoms, which affect the central nervous system. At the beginning of the year, researchers applied for a patent that the Bosch i Gimpera Foundation (FGB), based in the Parc Cient\u00edfic de Barcelona, licenced recently to the biotechnological company AB-Biotics.\" \/>\n<meta property=\"og:url\" content=\"https:\/\/www.pcb.ub.edu\/en\/the-bosch-i-gimpera-foundation-licences-a-patent-to-the-ab-biotics\/\" \/>\n<meta property=\"og:site_name\" content=\"Parc Cient\u00edfic de Barcelona\" \/>\n<meta property=\"article:published_time\" content=\"2013-10-29T23:00:00+00:00\" \/>\n<meta property=\"article:modified_time\" content=\"2020-11-18T13:53:32+00:00\" \/>\n<meta property=\"og:image\" content=\"http:\/\/www.pcb.ub.edu\/wp-content\/uploads\/2020\/11\/1383655001015.jpg\" \/>\n<meta name=\"author\" content=\"adminpcb\" \/>\n<meta name=\"twitter:card\" content=\"summary_large_image\" \/>\n<meta name=\"twitter:label1\" content=\"Written by\" \/>\n\t<meta name=\"twitter:data1\" content=\"adminpcb\" \/>\n\t<meta name=\"twitter:label2\" content=\"Est. reading time\" \/>\n\t<meta name=\"twitter:data2\" content=\"1 minute\" \/>\n<script type=\"application\/ld+json\" class=\"yoast-schema-graph\">{\"@context\":\"https:\/\/schema.org\",\"@graph\":[{\"@type\":\"WebPage\",\"@id\":\"https:\/\/www.pcb.ub.edu\/en\/the-bosch-i-gimpera-foundation-licences-a-patent-to-the-ab-biotics\/\",\"url\":\"https:\/\/www.pcb.ub.edu\/en\/the-bosch-i-gimpera-foundation-licences-a-patent-to-the-ab-biotics\/\",\"name\":\"The Bosch i Gimpera Foundation licences a patent to the AB-Biotics. - Parc Cient\u00edfic de Barcelona\",\"isPartOf\":{\"@id\":\"https:\/\/www.pcb.ub.edu\/es\/#website\"},\"primaryImageOfPage\":{\"@id\":\"https:\/\/www.pcb.ub.edu\/en\/the-bosch-i-gimpera-foundation-licences-a-patent-to-the-ab-biotics\/#primaryimage\"},\"image\":{\"@id\":\"https:\/\/www.pcb.ub.edu\/en\/the-bosch-i-gimpera-foundation-licences-a-patent-to-the-ab-biotics\/#primaryimage\"},\"thumbnailUrl\":\"http:\/\/www.pcb.ub.edu\/wp-content\/uploads\/2020\/11\/1383655001015.jpg\",\"datePublished\":\"2013-10-29T23:00:00+00:00\",\"dateModified\":\"2020-11-18T13:53:32+00:00\",\"author\":{\"@id\":\"https:\/\/www.pcb.ub.edu\/es\/#\/schema\/person\/d13cab05cd0a75b17fddca8496481021\"},\"breadcrumb\":{\"@id\":\"https:\/\/www.pcb.ub.edu\/en\/the-bosch-i-gimpera-foundation-licences-a-patent-to-the-ab-biotics\/#breadcrumb\"},\"inLanguage\":\"en-US\",\"potentialAction\":[{\"@type\":\"ReadAction\",\"target\":[\"https:\/\/www.pcb.ub.edu\/en\/the-bosch-i-gimpera-foundation-licences-a-patent-to-the-ab-biotics\/\"]}]},{\"@type\":\"ImageObject\",\"inLanguage\":\"en-US\",\"@id\":\"https:\/\/www.pcb.ub.edu\/en\/the-bosch-i-gimpera-foundation-licences-a-patent-to-the-ab-biotics\/#primaryimage\",\"url\":\"http:\/\/www.pcb.ub.edu\/wp-content\/uploads\/2020\/11\/1383655001015.jpg\",\"contentUrl\":\"http:\/\/www.pcb.ub.edu\/wp-content\/uploads\/2020\/11\/1383655001015.jpg\"},{\"@type\":\"BreadcrumbList\",\"@id\":\"https:\/\/www.pcb.ub.edu\/en\/the-bosch-i-gimpera-foundation-licences-a-patent-to-the-ab-biotics\/#breadcrumb\",\"itemListElement\":[{\"@type\":\"ListItem\",\"position\":1,\"name\":\"Home\",\"item\":\"https:\/\/www.pcb.ub.edu\/en\/\"},{\"@type\":\"ListItem\",\"position\":2,\"name\":\"The Bosch i Gimpera Foundation licences a patent to the AB-Biotics.\"}]},{\"@type\":\"WebSite\",\"@id\":\"https:\/\/www.pcb.ub.edu\/es\/#website\",\"url\":\"https:\/\/www.pcb.ub.edu\/es\/\",\"name\":\"Parc Cient\u00edfic de Barcelona\",\"description\":\"Universitat de Barcelona\",\"potentialAction\":[{\"@type\":\"SearchAction\",\"target\":{\"@type\":\"EntryPoint\",\"urlTemplate\":\"https:\/\/www.pcb.ub.edu\/es\/?s={search_term_string}\"},\"query-input\":{\"@type\":\"PropertyValueSpecification\",\"valueRequired\":true,\"valueName\":\"search_term_string\"}}],\"inLanguage\":\"en-US\"},{\"@type\":\"Person\",\"@id\":\"https:\/\/www.pcb.ub.edu\/es\/#\/schema\/person\/d13cab05cd0a75b17fddca8496481021\",\"name\":\"adminpcb\",\"image\":{\"@type\":\"ImageObject\",\"inLanguage\":\"en-US\",\"@id\":\"https:\/\/www.pcb.ub.edu\/es\/#\/schema\/person\/image\/\",\"url\":\"https:\/\/secure.gravatar.com\/avatar\/41ad0fab4bb3bf5348b0af9612159cfd93173a57bbca98fecb50fa6f3ab97d28?s=96&d=mm&r=g\",\"contentUrl\":\"https:\/\/secure.gravatar.com\/avatar\/41ad0fab4bb3bf5348b0af9612159cfd93173a57bbca98fecb50fa6f3ab97d28?s=96&d=mm&r=g\",\"caption\":\"adminpcb\"},\"url\":\"https:\/\/www.pcb.ub.edu\/en\/author\/adminpcb\/\"}]}<\/script>\n<!-- \/ Yoast SEO plugin. -->","yoast_head_json":{"title":"The Bosch i Gimpera Foundation licences a patent to the AB-Biotics. - Parc Cient\u00edfic de Barcelona","robots":{"index":"index","follow":"follow","max-snippet":"max-snippet:-1","max-image-preview":"max-image-preview:large","max-video-preview":"max-video-preview:-1"},"canonical":"https:\/\/www.pcb.ub.edu\/en\/the-bosch-i-gimpera-foundation-licences-a-patent-to-the-ab-biotics\/","og_locale":"en_US","og_type":"article","og_title":"The Bosch i Gimpera Foundation licences a patent to the AB-Biotics. - Parc Cient\u00edfic de Barcelona","og_description":"The University of Barcelona (UB), the August Pi i Sunyer Biomedical Research Institute (IDIBAPS), the Hospital Cl\u00ednic of Barcelona and the Centre for Biomedical Network Research on Mental Health (CIBERSAM) have developed a technology that allows to predict if the risk of a patient treated with antipsychotic drugs developing extrapyramidal symptoms, which affect the central nervous system. At the beginning of the year, researchers applied for a patent that the Bosch i Gimpera Foundation (FGB), based in the Parc Cient\u00edfic de Barcelona, licenced recently to the biotechnological company AB-Biotics.","og_url":"https:\/\/www.pcb.ub.edu\/en\/the-bosch-i-gimpera-foundation-licences-a-patent-to-the-ab-biotics\/","og_site_name":"Parc Cient\u00edfic de Barcelona","article_published_time":"2013-10-29T23:00:00+00:00","article_modified_time":"2020-11-18T13:53:32+00:00","og_image":[{"url":"http:\/\/www.pcb.ub.edu\/wp-content\/uploads\/2020\/11\/1383655001015.jpg","type":"","width":"","height":""}],"author":"adminpcb","twitter_card":"summary_large_image","twitter_misc":{"Written by":"adminpcb","Est. reading time":"1 minute"},"schema":{"@context":"https:\/\/schema.org","@graph":[{"@type":"WebPage","@id":"https:\/\/www.pcb.ub.edu\/en\/the-bosch-i-gimpera-foundation-licences-a-patent-to-the-ab-biotics\/","url":"https:\/\/www.pcb.ub.edu\/en\/the-bosch-i-gimpera-foundation-licences-a-patent-to-the-ab-biotics\/","name":"The Bosch i Gimpera Foundation licences a patent to the AB-Biotics. - Parc Cient\u00edfic de Barcelona","isPartOf":{"@id":"https:\/\/www.pcb.ub.edu\/es\/#website"},"primaryImageOfPage":{"@id":"https:\/\/www.pcb.ub.edu\/en\/the-bosch-i-gimpera-foundation-licences-a-patent-to-the-ab-biotics\/#primaryimage"},"image":{"@id":"https:\/\/www.pcb.ub.edu\/en\/the-bosch-i-gimpera-foundation-licences-a-patent-to-the-ab-biotics\/#primaryimage"},"thumbnailUrl":"http:\/\/www.pcb.ub.edu\/wp-content\/uploads\/2020\/11\/1383655001015.jpg","datePublished":"2013-10-29T23:00:00+00:00","dateModified":"2020-11-18T13:53:32+00:00","author":{"@id":"https:\/\/www.pcb.ub.edu\/es\/#\/schema\/person\/d13cab05cd0a75b17fddca8496481021"},"breadcrumb":{"@id":"https:\/\/www.pcb.ub.edu\/en\/the-bosch-i-gimpera-foundation-licences-a-patent-to-the-ab-biotics\/#breadcrumb"},"inLanguage":"en-US","potentialAction":[{"@type":"ReadAction","target":["https:\/\/www.pcb.ub.edu\/en\/the-bosch-i-gimpera-foundation-licences-a-patent-to-the-ab-biotics\/"]}]},{"@type":"ImageObject","inLanguage":"en-US","@id":"https:\/\/www.pcb.ub.edu\/en\/the-bosch-i-gimpera-foundation-licences-a-patent-to-the-ab-biotics\/#primaryimage","url":"http:\/\/www.pcb.ub.edu\/wp-content\/uploads\/2020\/11\/1383655001015.jpg","contentUrl":"http:\/\/www.pcb.ub.edu\/wp-content\/uploads\/2020\/11\/1383655001015.jpg"},{"@type":"BreadcrumbList","@id":"https:\/\/www.pcb.ub.edu\/en\/the-bosch-i-gimpera-foundation-licences-a-patent-to-the-ab-biotics\/#breadcrumb","itemListElement":[{"@type":"ListItem","position":1,"name":"Home","item":"https:\/\/www.pcb.ub.edu\/en\/"},{"@type":"ListItem","position":2,"name":"The Bosch i Gimpera Foundation licences a patent to the AB-Biotics."}]},{"@type":"WebSite","@id":"https:\/\/www.pcb.ub.edu\/es\/#website","url":"https:\/\/www.pcb.ub.edu\/es\/","name":"Parc Cient\u00edfic de Barcelona","description":"Universitat de Barcelona","potentialAction":[{"@type":"SearchAction","target":{"@type":"EntryPoint","urlTemplate":"https:\/\/www.pcb.ub.edu\/es\/?s={search_term_string}"},"query-input":{"@type":"PropertyValueSpecification","valueRequired":true,"valueName":"search_term_string"}}],"inLanguage":"en-US"},{"@type":"Person","@id":"https:\/\/www.pcb.ub.edu\/es\/#\/schema\/person\/d13cab05cd0a75b17fddca8496481021","name":"adminpcb","image":{"@type":"ImageObject","inLanguage":"en-US","@id":"https:\/\/www.pcb.ub.edu\/es\/#\/schema\/person\/image\/","url":"https:\/\/secure.gravatar.com\/avatar\/41ad0fab4bb3bf5348b0af9612159cfd93173a57bbca98fecb50fa6f3ab97d28?s=96&d=mm&r=g","contentUrl":"https:\/\/secure.gravatar.com\/avatar\/41ad0fab4bb3bf5348b0af9612159cfd93173a57bbca98fecb50fa6f3ab97d28?s=96&d=mm&r=g","caption":"adminpcb"},"url":"https:\/\/www.pcb.ub.edu\/en\/author\/adminpcb\/"}]}},"_links":{"self":[{"href":"https:\/\/www.pcb.ub.edu\/en\/wp-json\/wp\/v2\/posts\/48618","targetHints":{"allow":["GET"]}}],"collection":[{"href":"https:\/\/www.pcb.ub.edu\/en\/wp-json\/wp\/v2\/posts"}],"about":[{"href":"https:\/\/www.pcb.ub.edu\/en\/wp-json\/wp\/v2\/types\/post"}],"author":[{"embeddable":true,"href":"https:\/\/www.pcb.ub.edu\/en\/wp-json\/wp\/v2\/users\/1"}],"replies":[{"embeddable":true,"href":"https:\/\/www.pcb.ub.edu\/en\/wp-json\/wp\/v2\/comments?post=48618"}],"version-history":[{"count":1,"href":"https:\/\/www.pcb.ub.edu\/en\/wp-json\/wp\/v2\/posts\/48618\/revisions"}],"predecessor-version":[{"id":52532,"href":"https:\/\/www.pcb.ub.edu\/en\/wp-json\/wp\/v2\/posts\/48618\/revisions\/52532"}],"wp:attachment":[{"href":"https:\/\/www.pcb.ub.edu\/en\/wp-json\/wp\/v2\/media?parent=48618"}],"wp:term":[{"taxonomy":"category","embeddable":true,"href":"https:\/\/www.pcb.ub.edu\/en\/wp-json\/wp\/v2\/categories?post=48618"},{"taxonomy":"post_tag","embeddable":true,"href":"https:\/\/www.pcb.ub.edu\/en\/wp-json\/wp\/v2\/tags?post=48618"}],"curies":[{"name":"wp","href":"https:\/\/api.w.org\/{rel}","templated":true}]}}